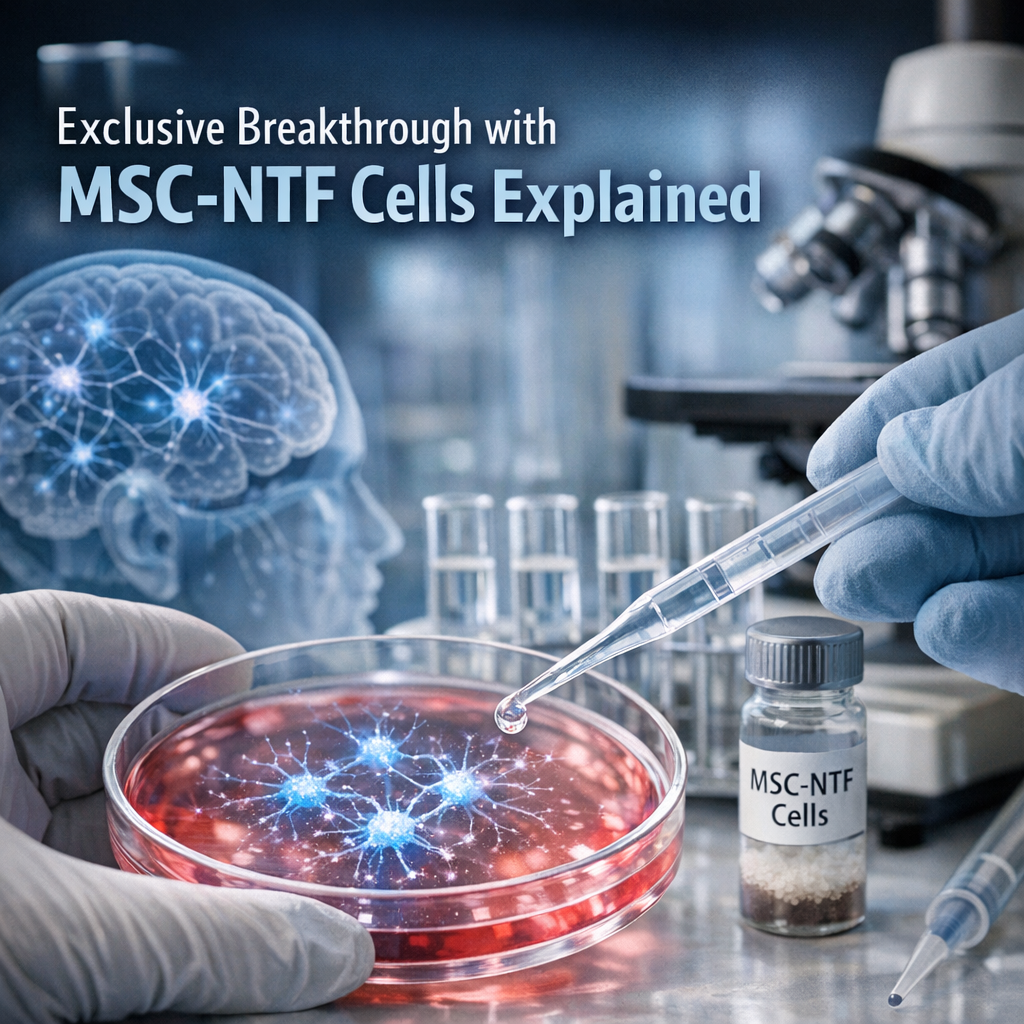
Illustration of NurOwn ALS: Exclusive Breakthrough with MSC-NTF Cells Explained

ALS Eye Gaze Tech: Effortless Control with Tobii Dynavox
ALS eye gaze tech like Tobii Dynavox is opening up a world of communication and independence for people with ALS, allowing effortless control of devices using only their eyes. Discover how this innovative technology brings comfort and autonomy back into daily life.